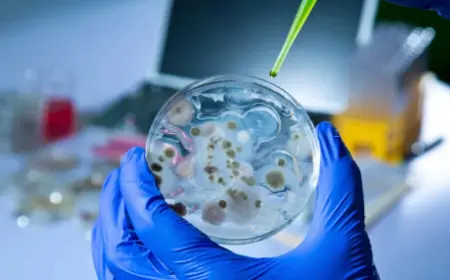
ŠIRI SE OPASNA ZARAZA: BOLEST POTVRĐENA I U HRVATSKOM SUSJEDSTVU

Zadarski portal koristi kolačiće (cookies) za poboljšanje korisničkog iskustva. Postavke kolačića mogu se kontrolirati i podešavati u vašem web pregledniku. Nastavkom pregleda web stranice Zadarski portal, slažete se s korištenjem kolačića. Za nastavak pregleda i korištenja web stranice Zadarski portal, molimo kliknite na gumb "Slažem se".